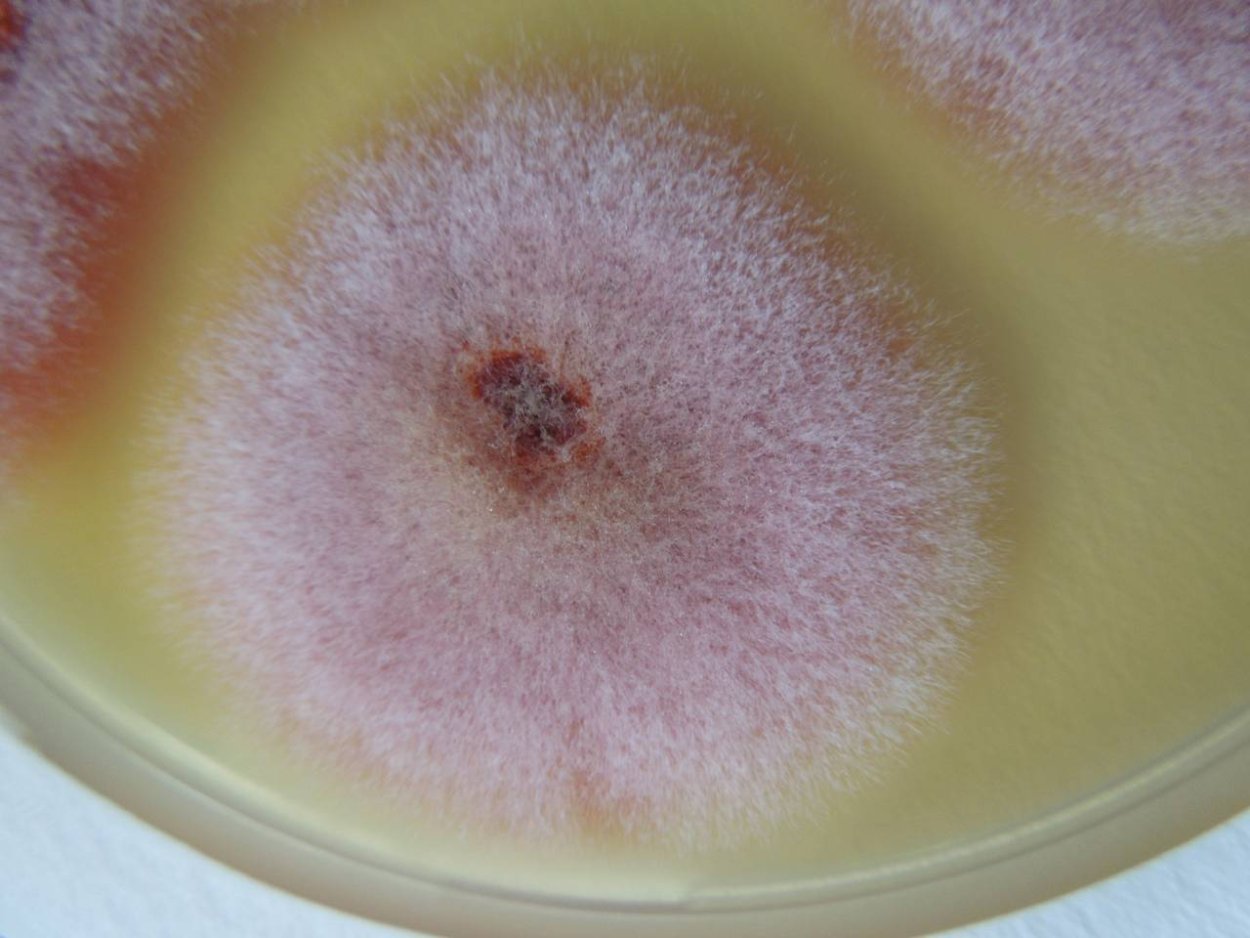
Плесневые грибы фузариум
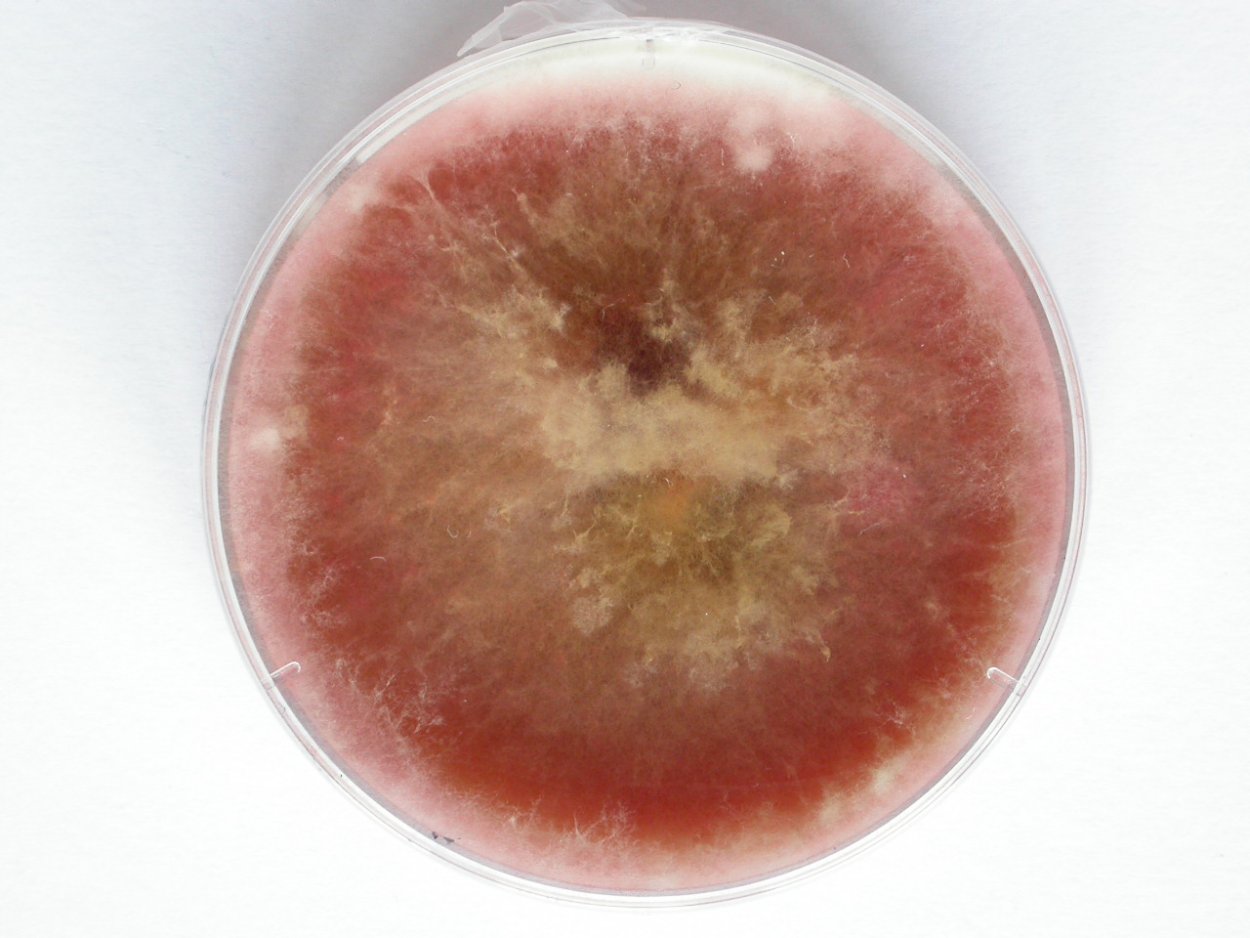
Фузариум споротрихиелла
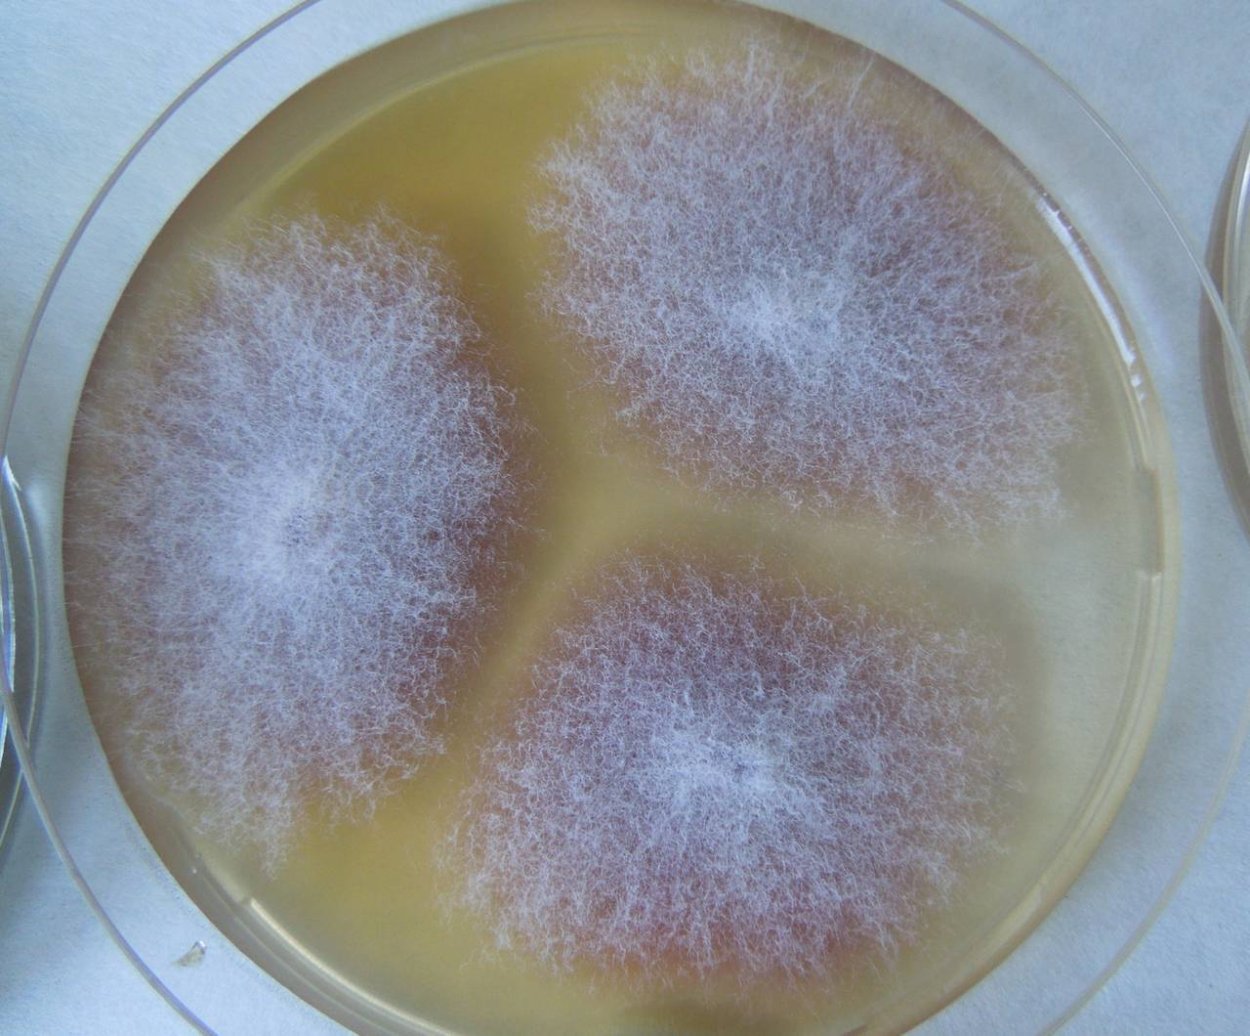
Fusarium гриб
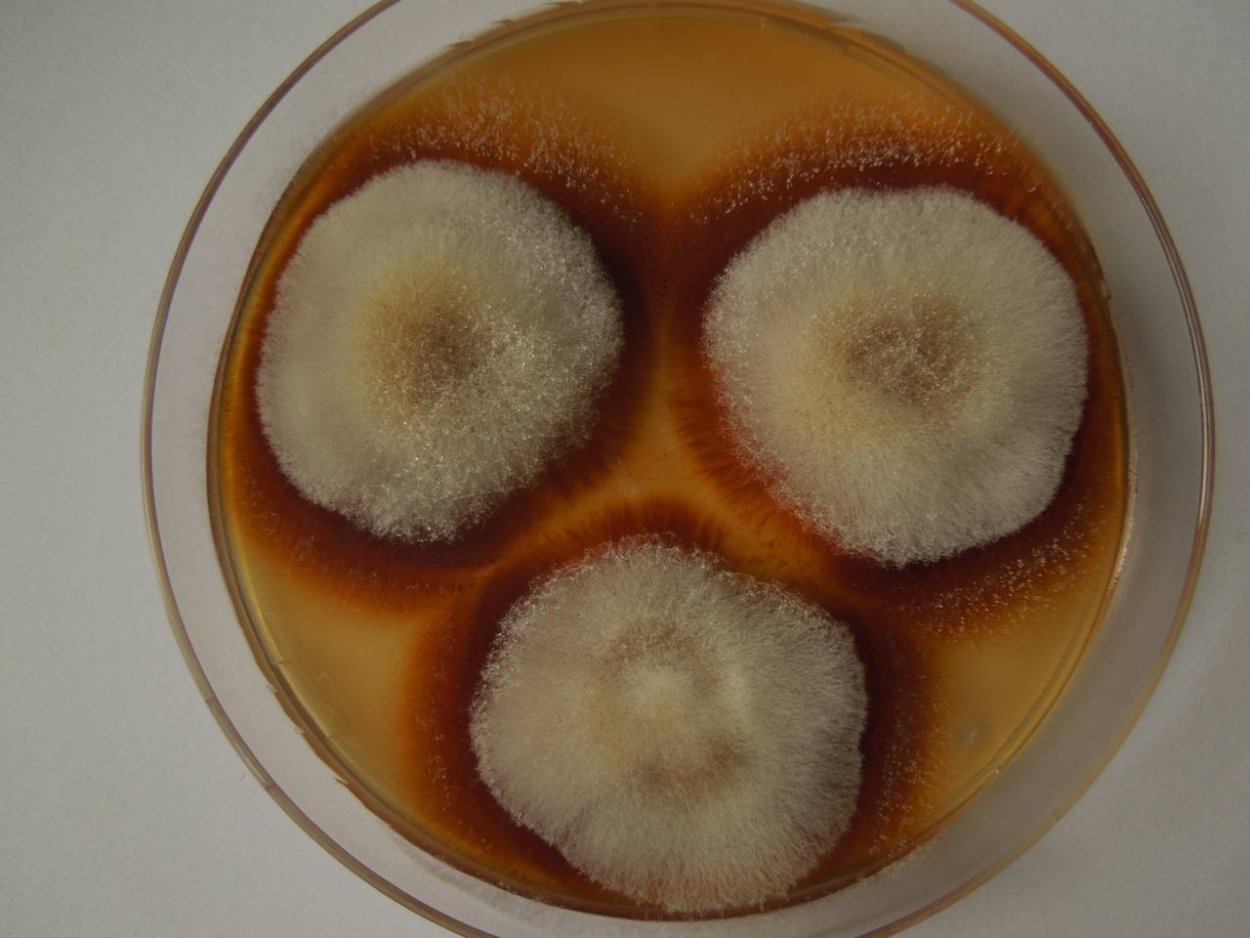
Фузариум Солани
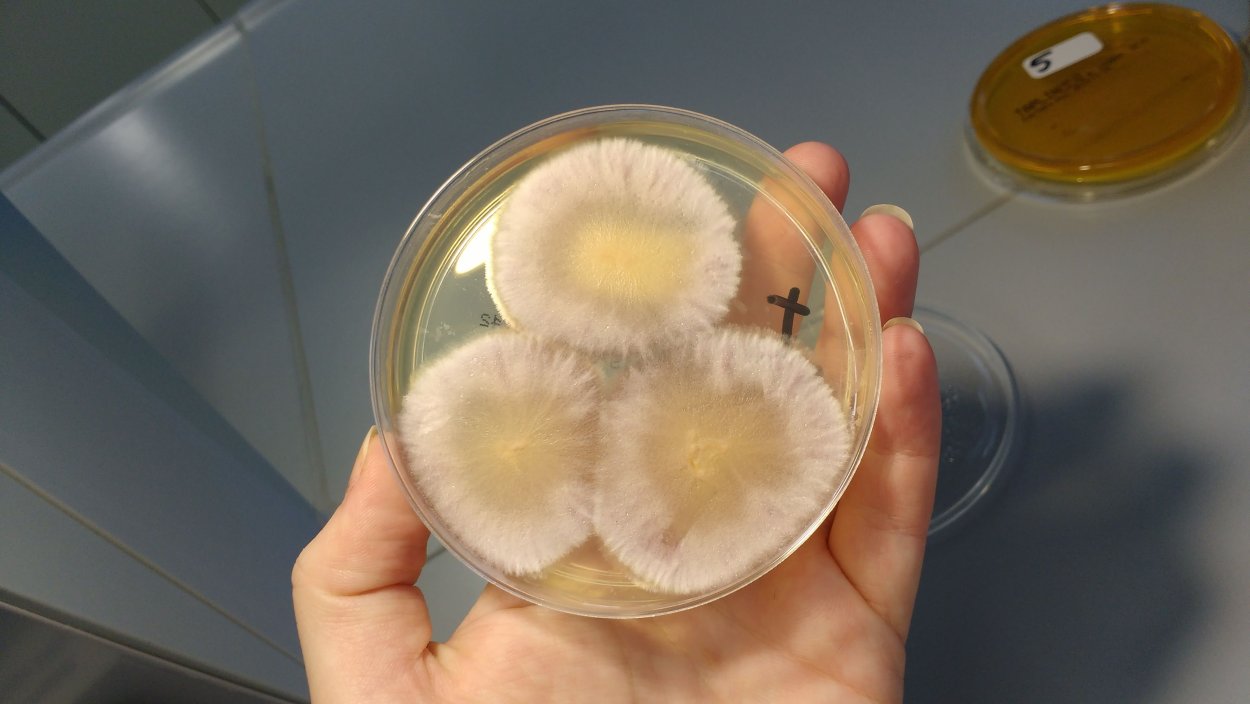
Fusarium oxysporum
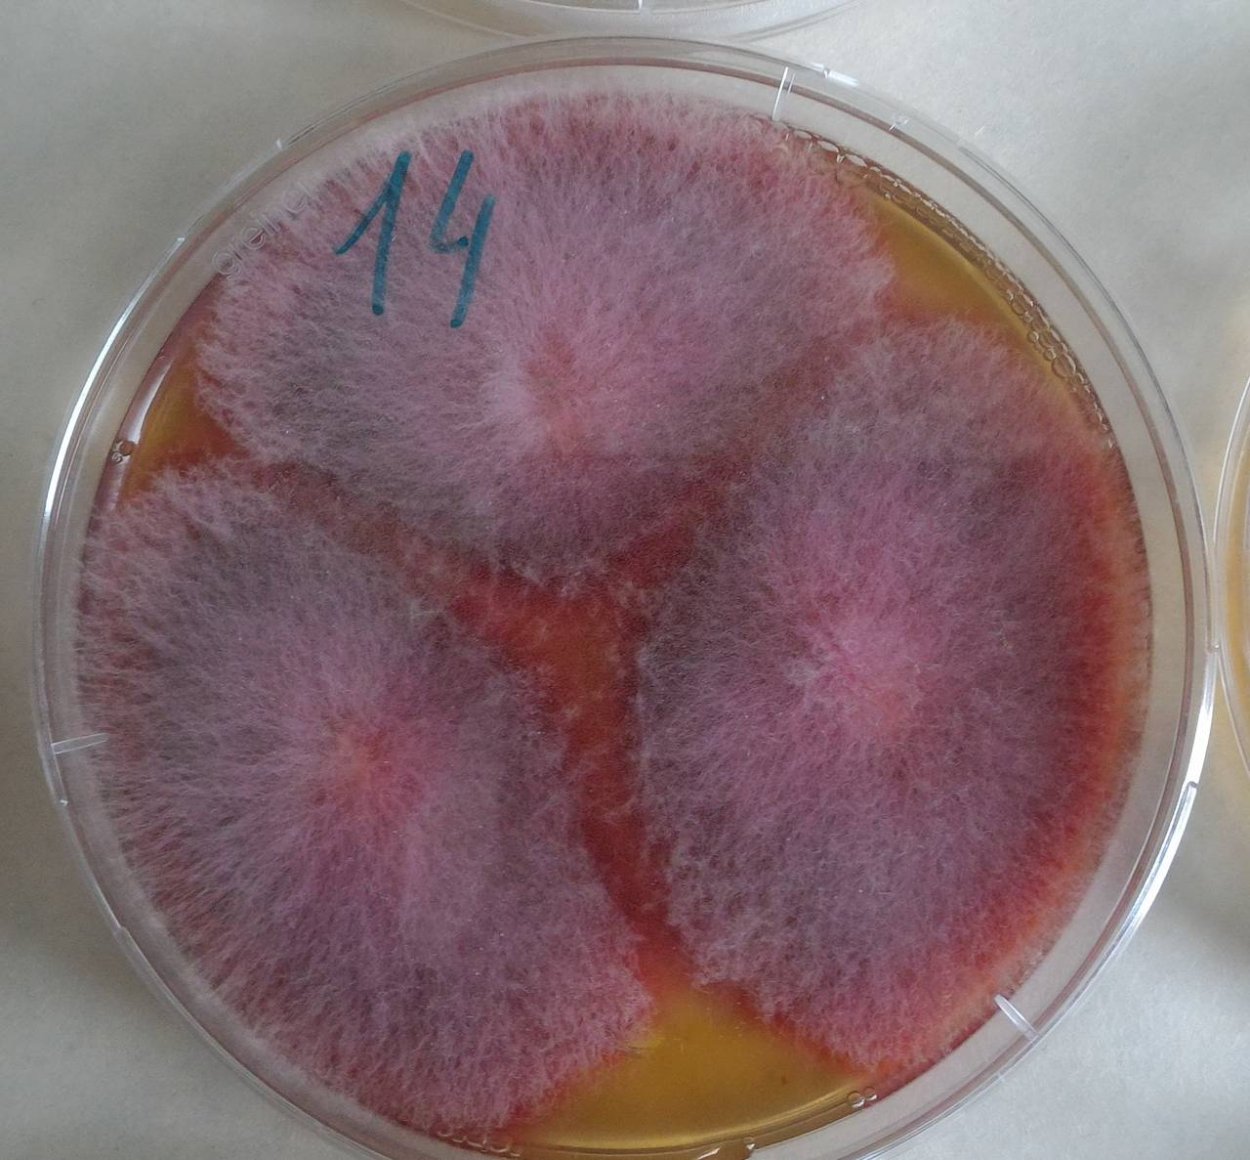
Штамм Fusarium graminearum
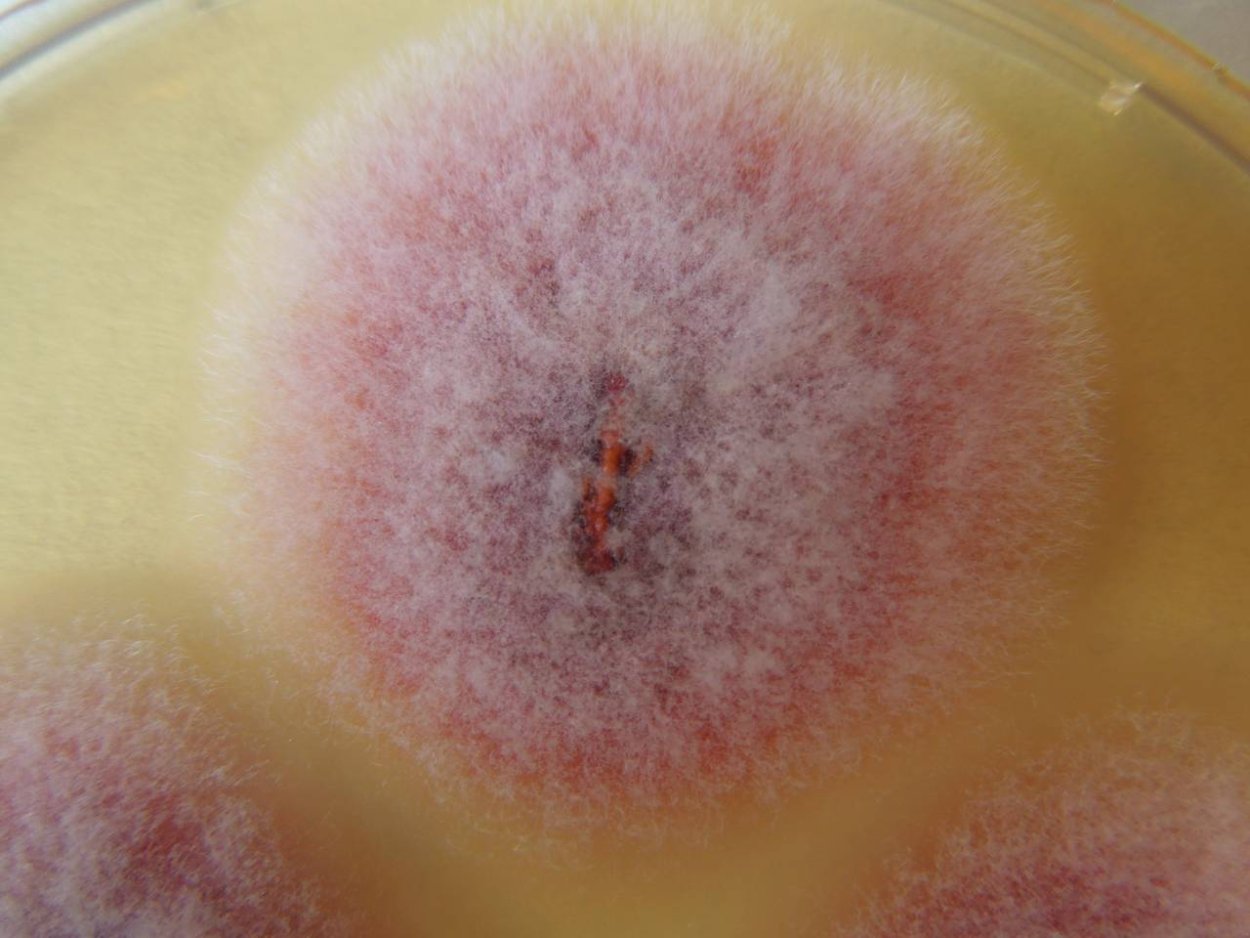
Фузариум гриб
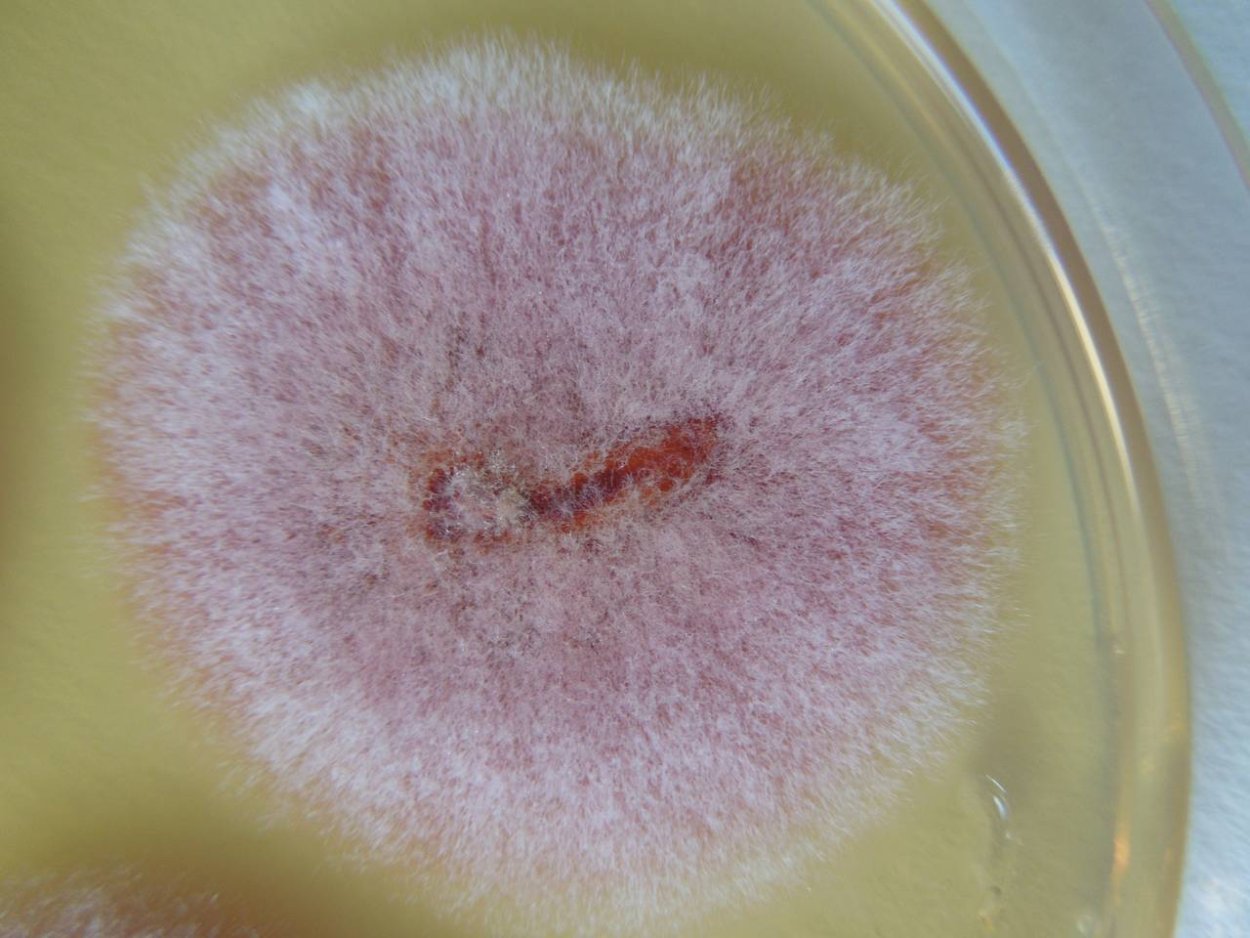
Плесневые грибы фузариум
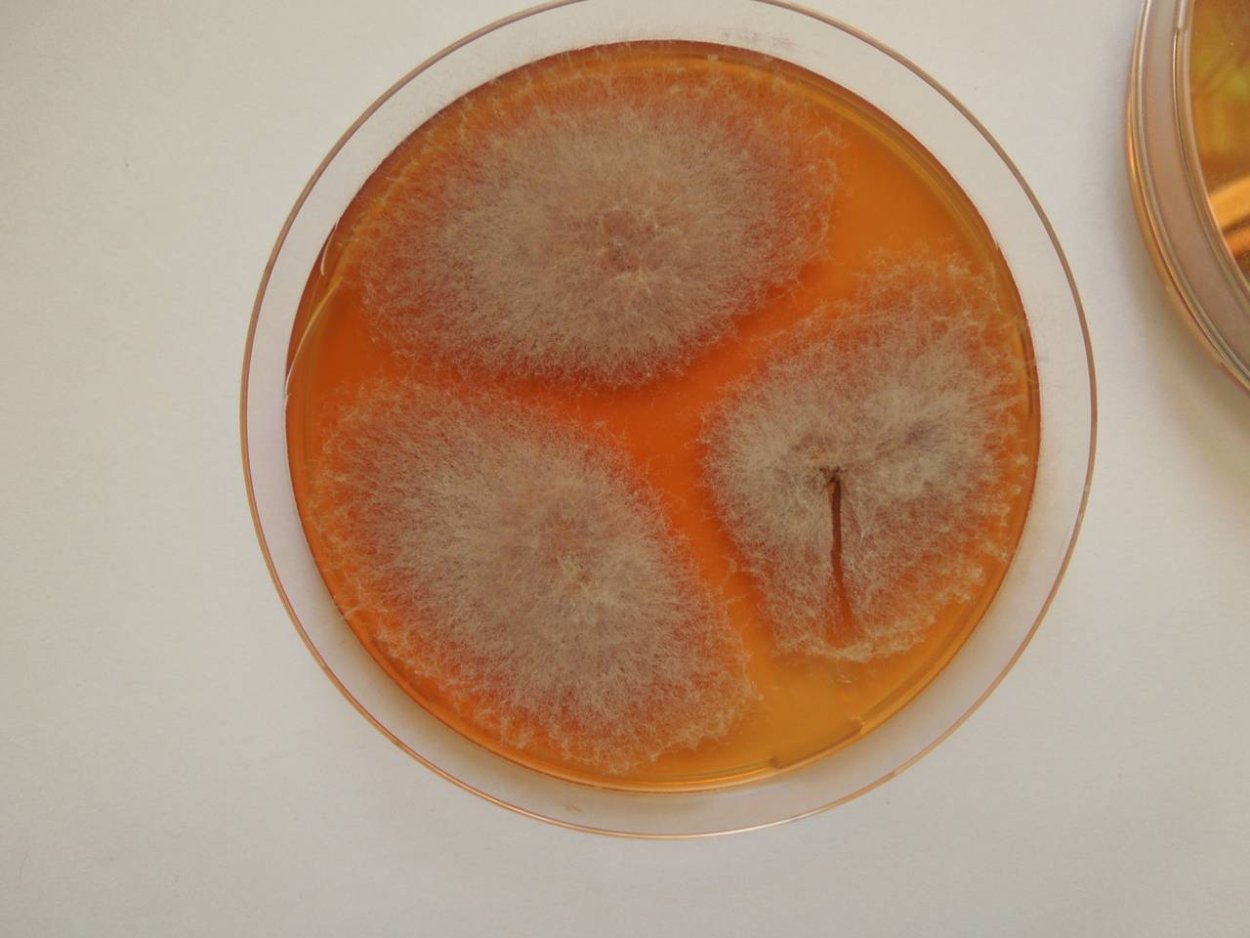
Фузариум самбуцинум
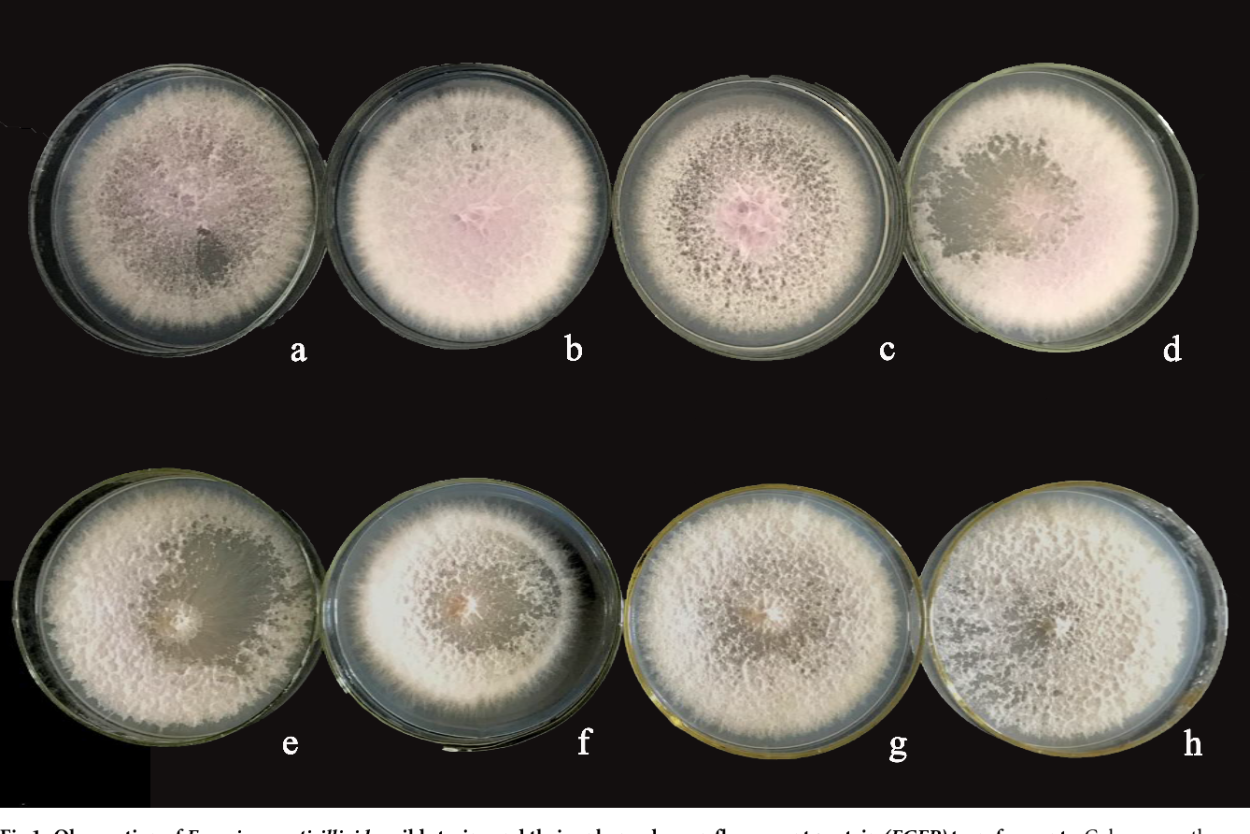
Fusarium verticillioides
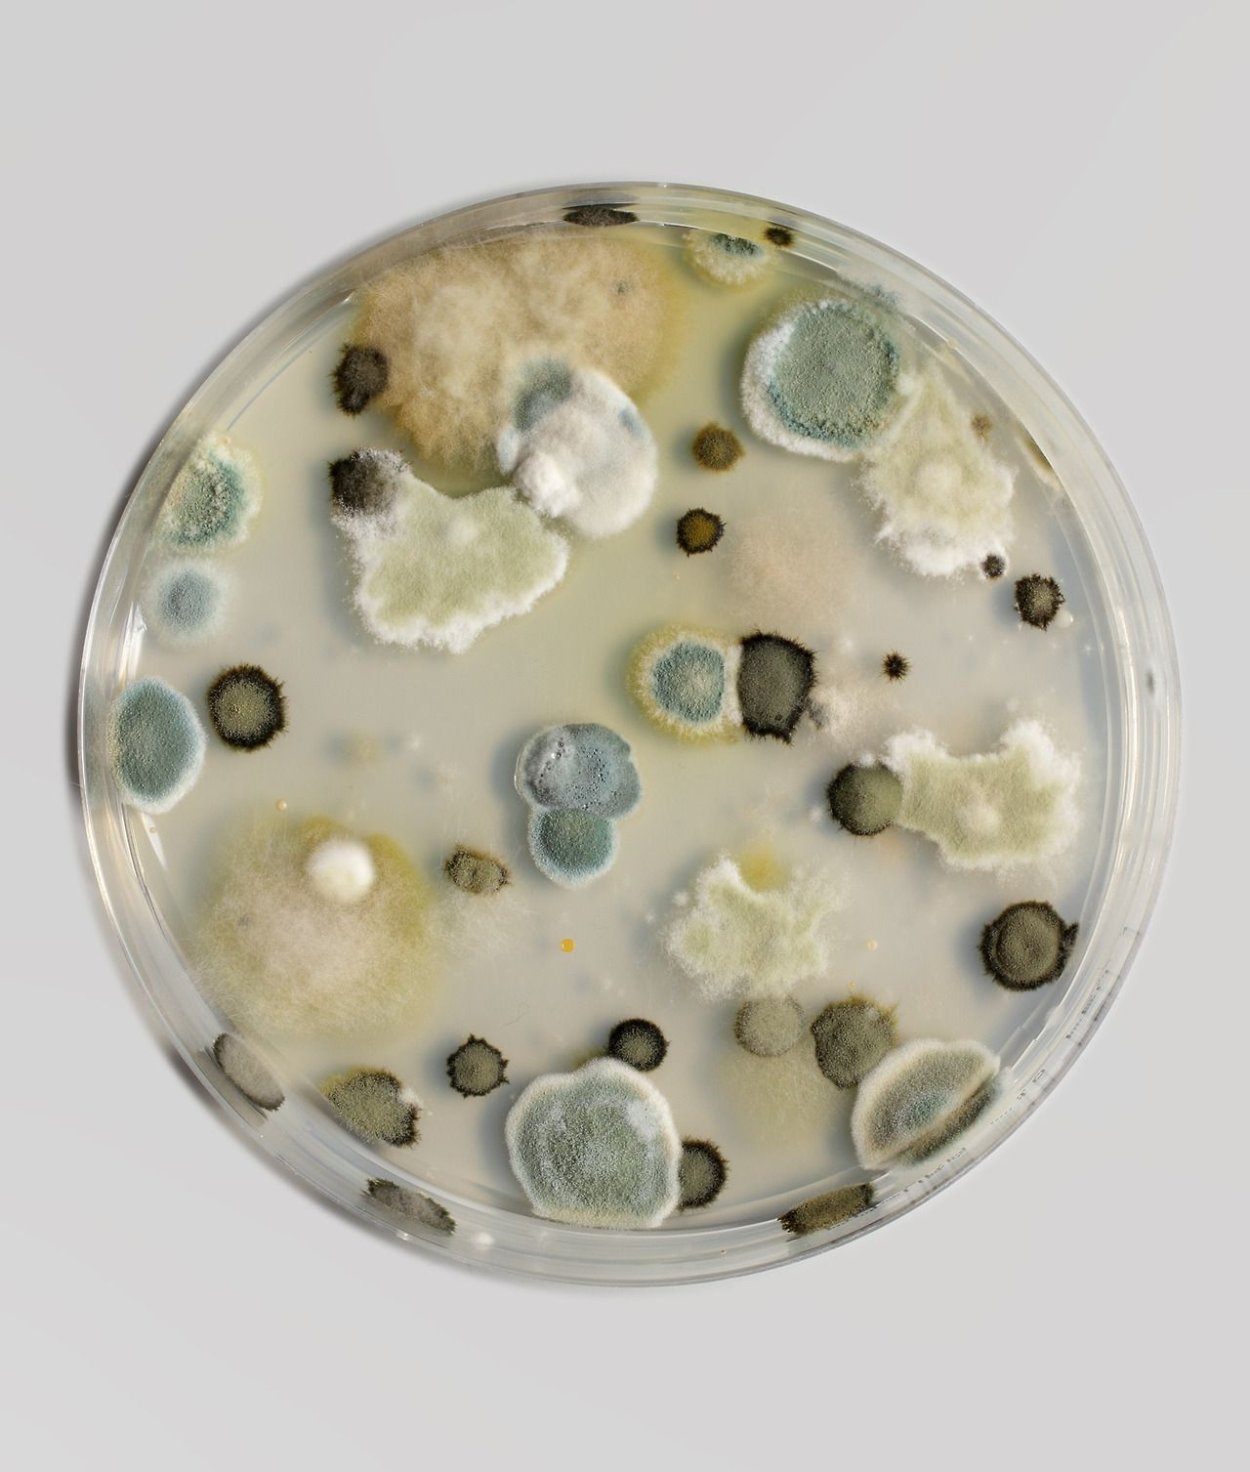
Плесневые грибы в чашке Петри
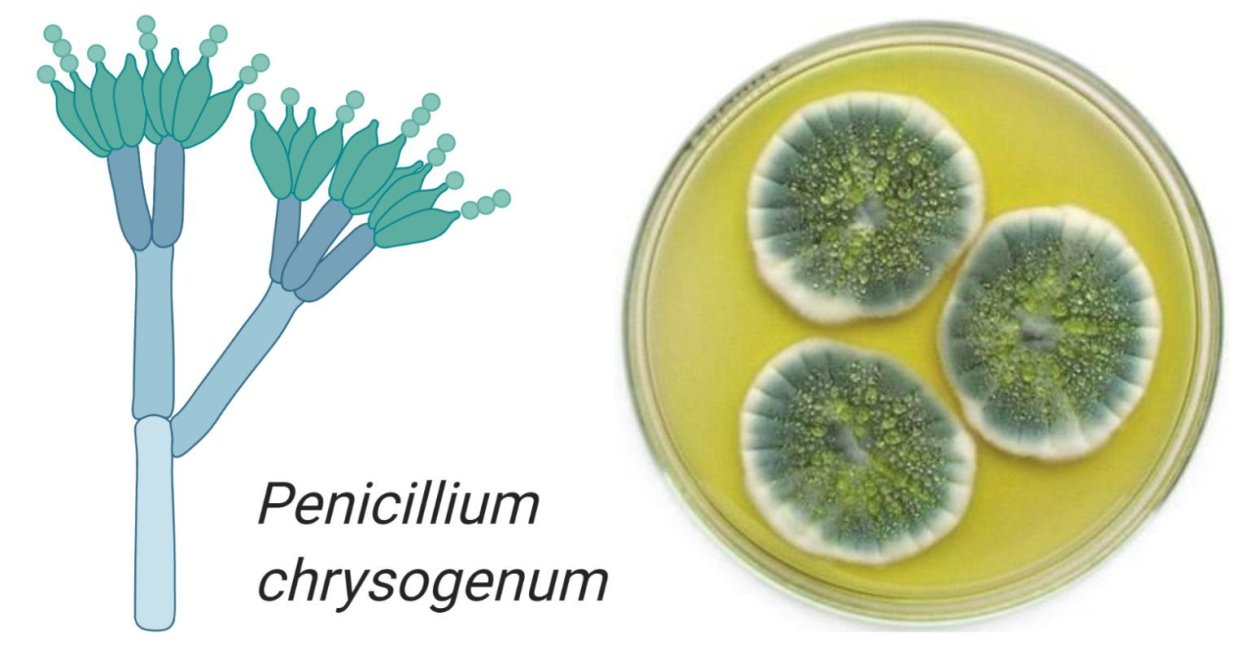
Penicillium notatum пенициллин
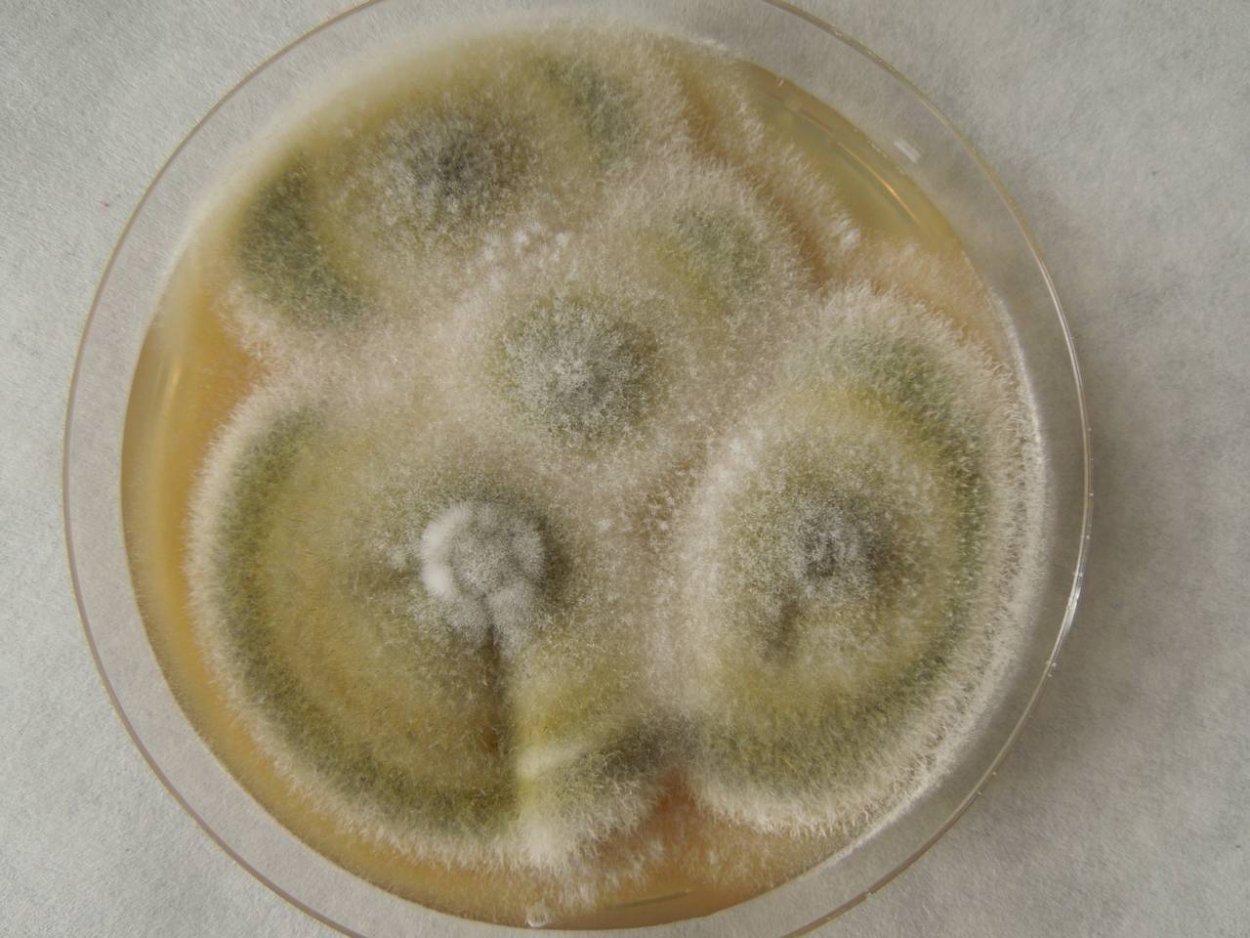
Грибы рода Fusarium culmorum
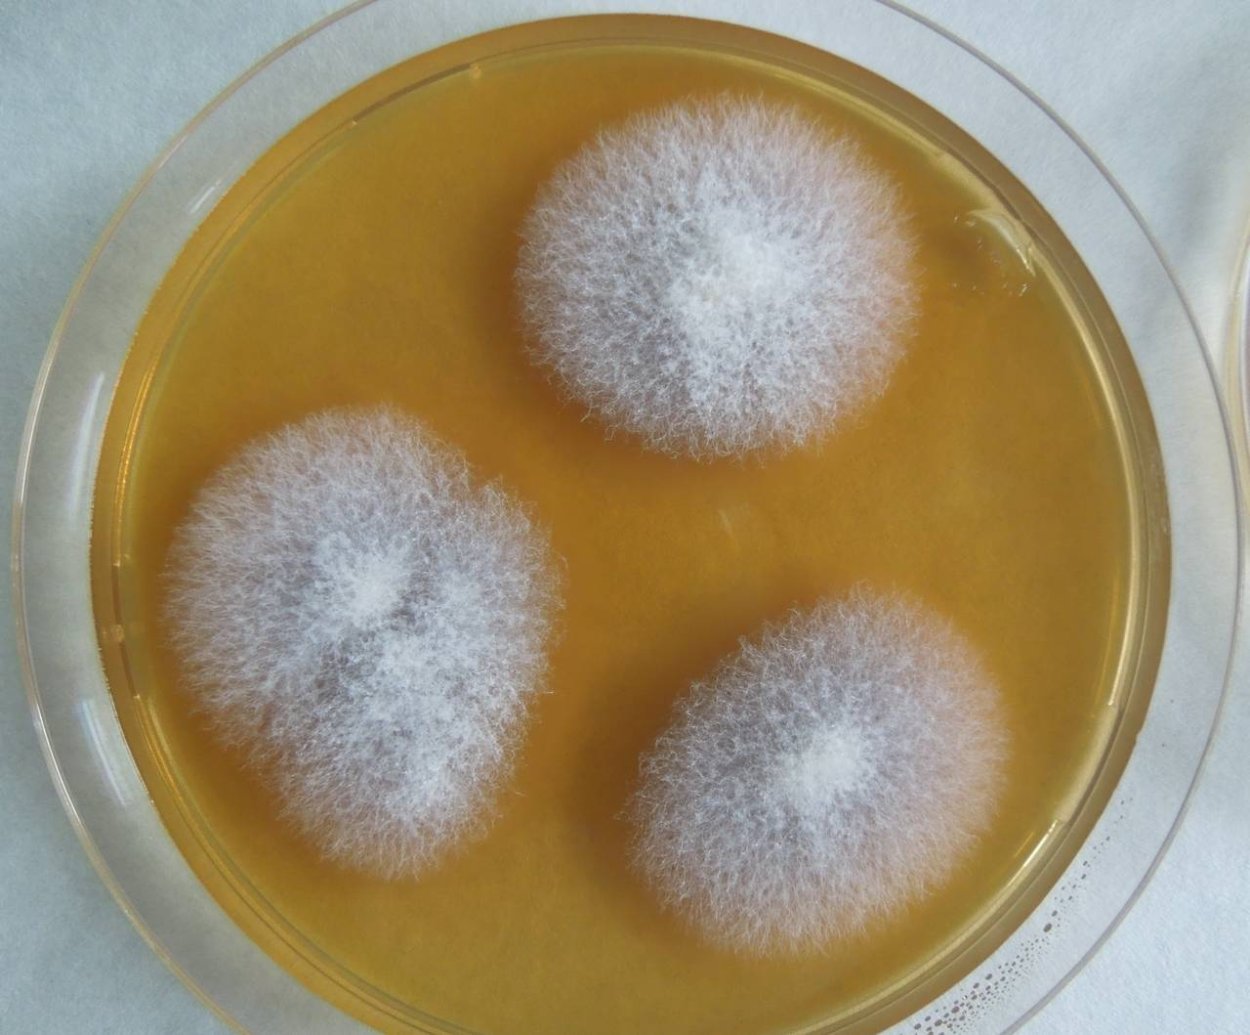
Фузариум споротрихиелла
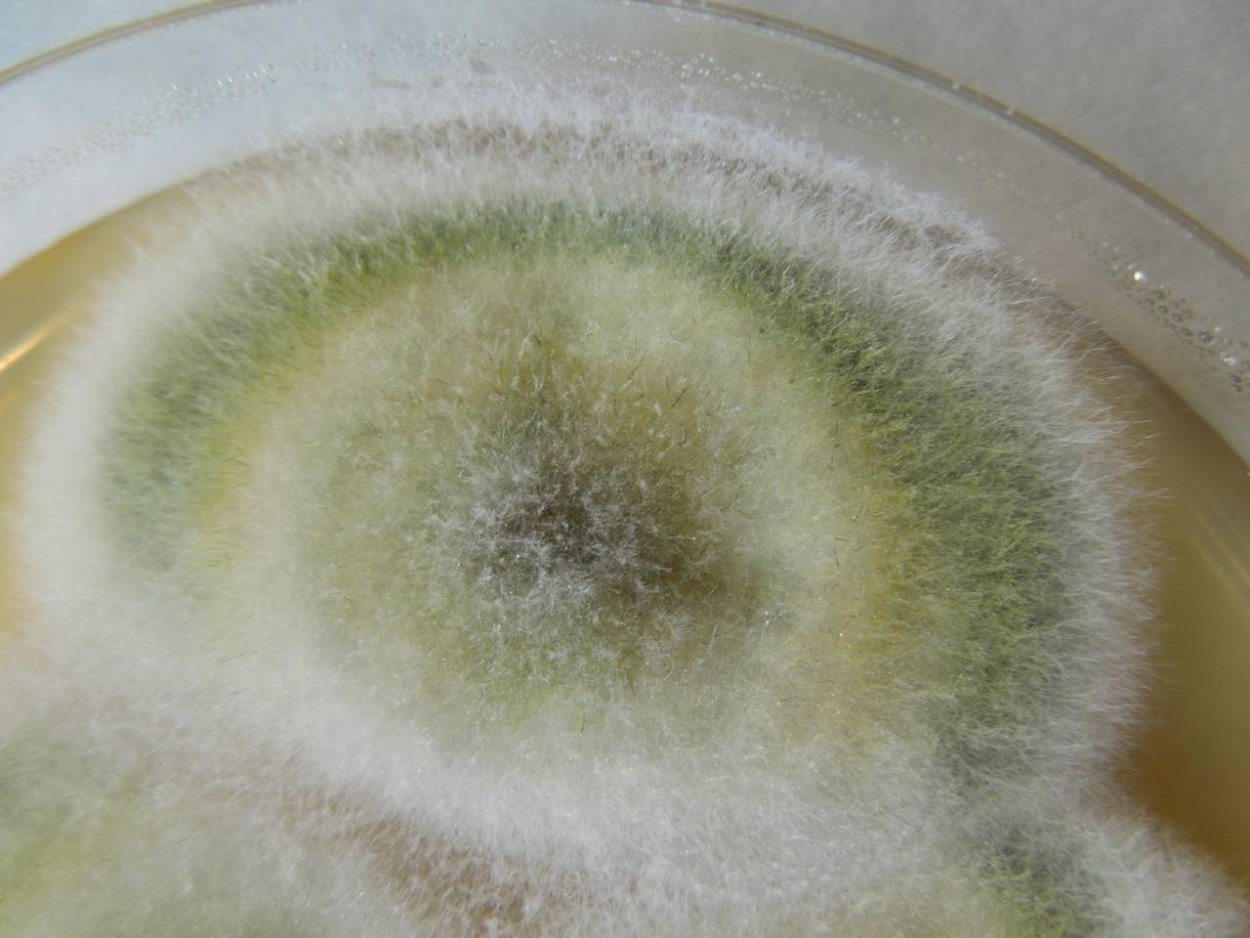
Фузариум Солани
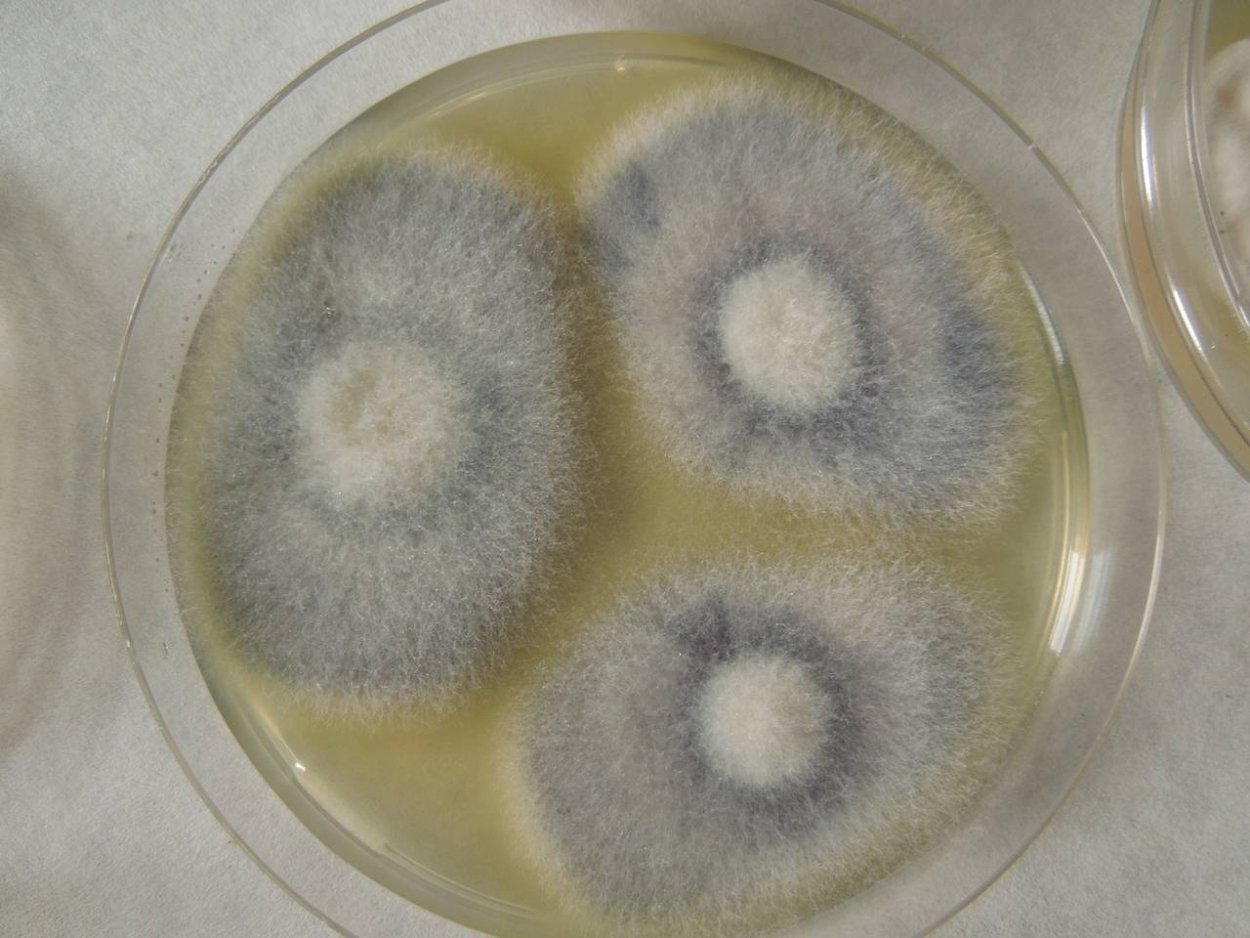
Грибы рода фузариум
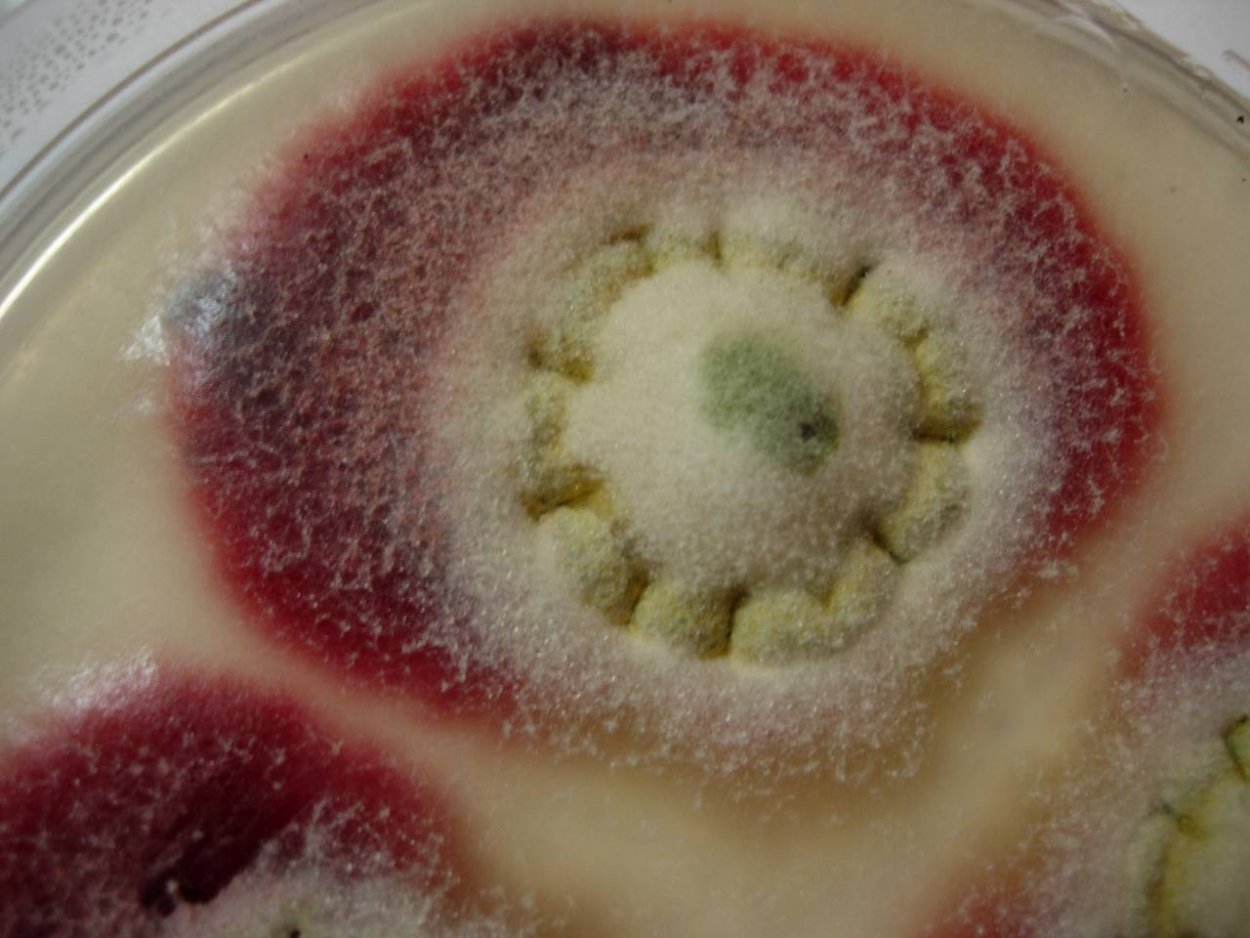
Fusarium sambucinum
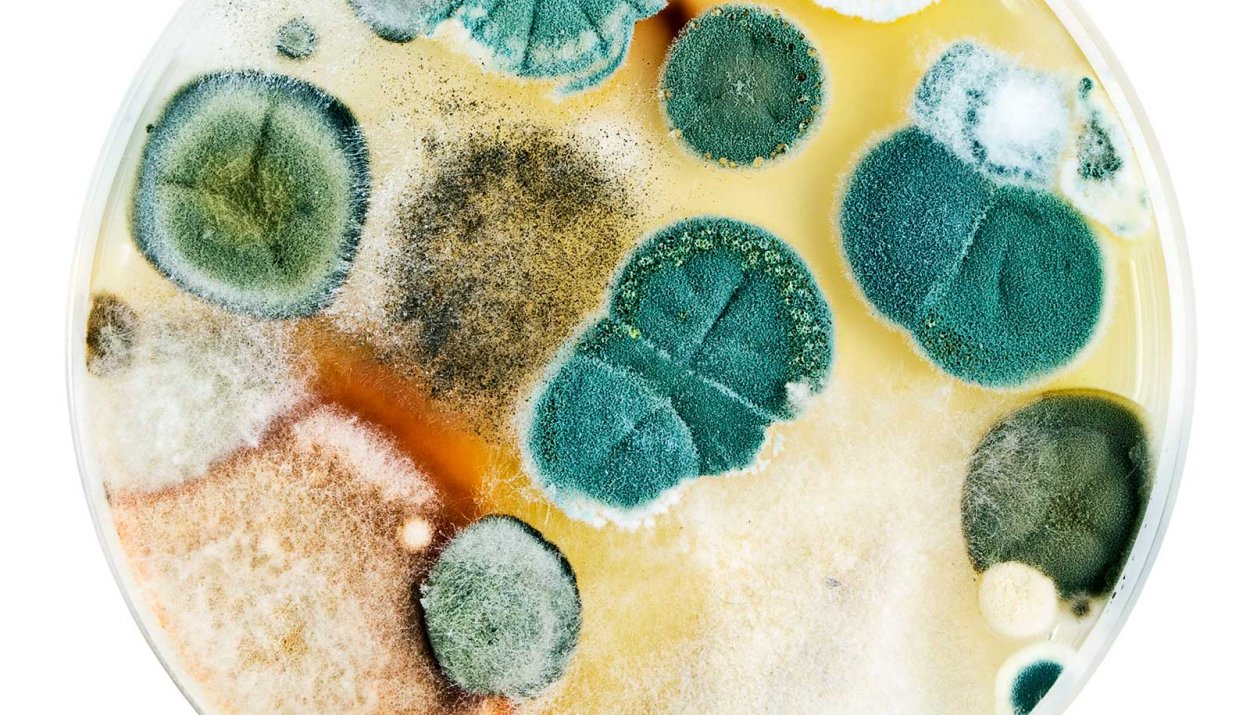
Белый грибок чашка Петри
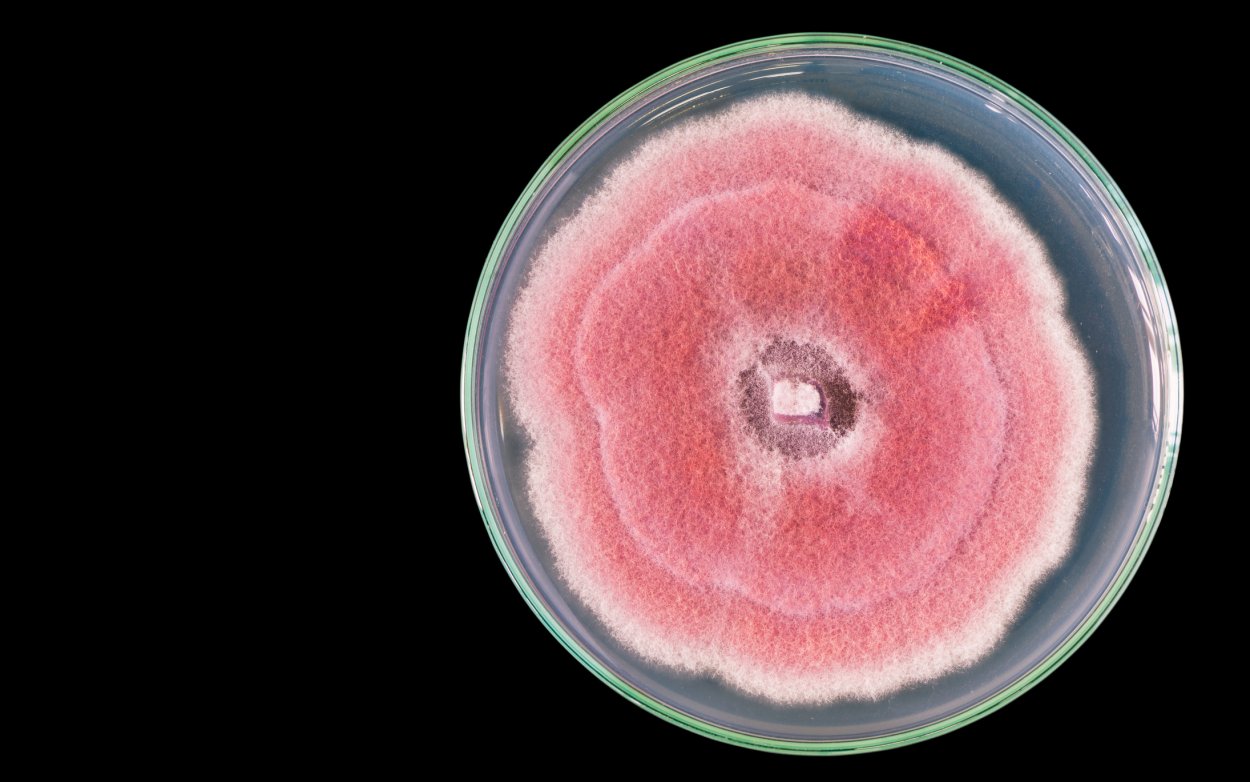
Плесневый гриб чашка Петри
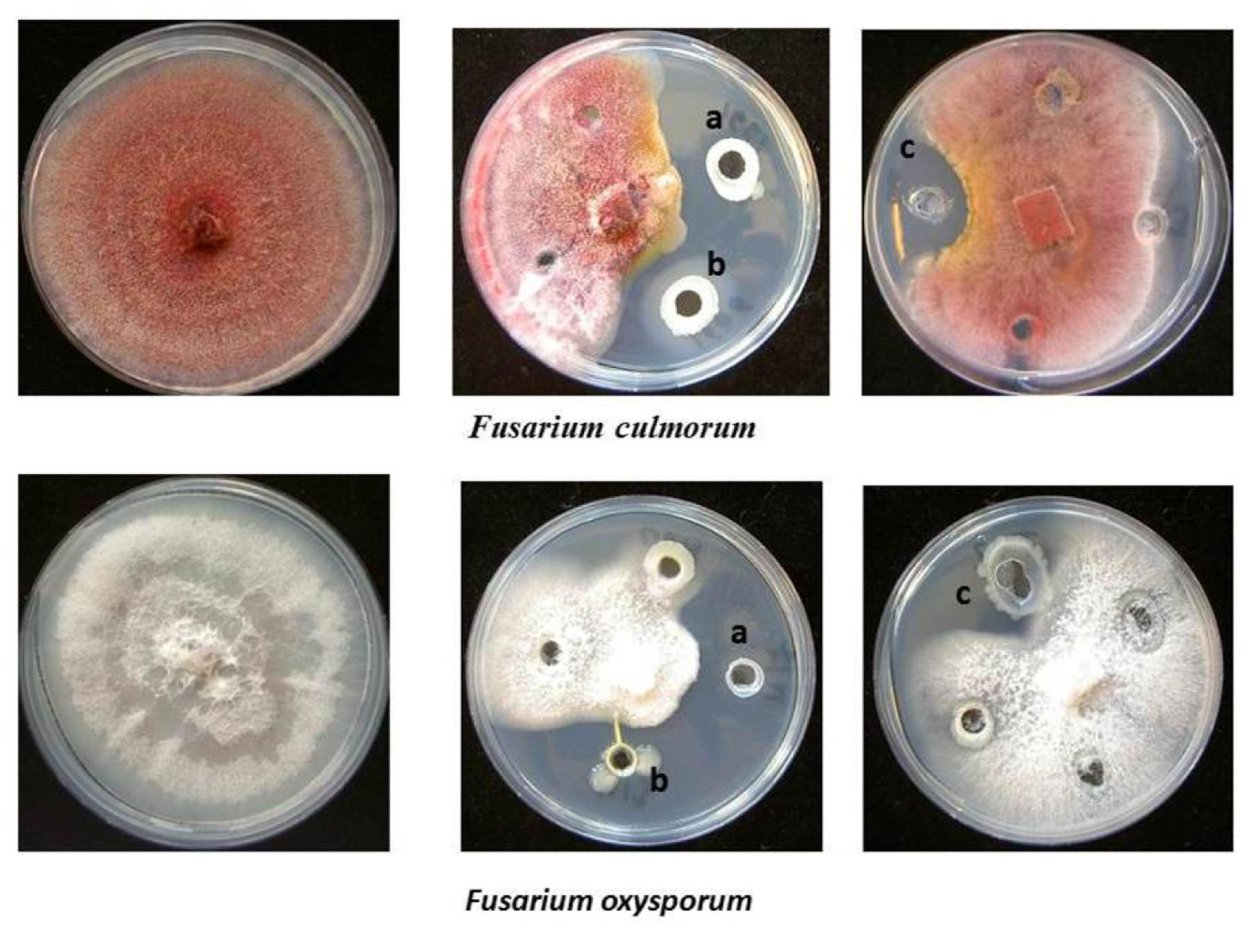
Фузариум кульморум

Гриб фузариум

Фузариум микробиология
Плесневые грибы фузариум

Fusarium oxysporum (1-й диапазон)

Claviceps purpurea – спорынья пурпурная

Конидии Fusarium
Фузариум споротрихиелла

Fusarium verticillioides
Fusarium гриб

Botrytis cinerea микроскоп

Дрожжеподобный грибок кандида

Грибы на чашке Петри Сабуро
Фузариум Солани
Fusarium oxysporum

Aspergillus и Penicillium
Штамм Fusarium graminearum

Колонии микроорганизмов в чашке Петри

Fusarium fujikuroi

Остаток ложный цветок

Колонии микроорганизмов в чашке Петри

Спороношение фузариума
Фузариум гриб

Фузариум конидии
Плесневые грибы фузариум
Фузариум самбуцинум

Плесень в чашке Петри
Fusarium verticillioides

Фузариум микроскопия
Плесневые грибы в чашке Петри

Плесень аспергиллус

Физарум ПОЛИЦЕФАЛУМ

Фузариум Ксерофиллум

Оидии артроспоры
Penicillium notatum пенициллин
Грибы рода Fusarium culmorum

Жизненный цикл базидиальных грибов

Плесень на пшенице

Гриб Fusarium oxysporum

Альтернария (Alternaria)

Афлатоксины аспергилла

Фузариум оксиспорум

Fusarium, Chaetomium
Фузариум споротрихиелла

Гриб Cephalosporium Acremonium
Фузариум Солани

Микробиология Penicillium Aspergillus
Грибы рода фузариум

Фузариум Солани

Микроскопические грибы микробиология

Alternaria humicola

Чашка Петри с агаром

Фузариум строение

Аспергилл в чашке Петри

Fusarium хламидоспоры
Fusarium sambucinum
Белый грибок чашка Петри
Плесневый гриб чашка Петри

Aspergillus flavus Токсин

Фузариум споротрихиелла

Acremonium chrysogenum
Фузариум кульморум

Fusarium oxysporum (1-й диапазон)

Самые редкие грибы в России

Грибы рода фузариум

Физарум ПОЛИЦЕФАЛУМ

Грибы